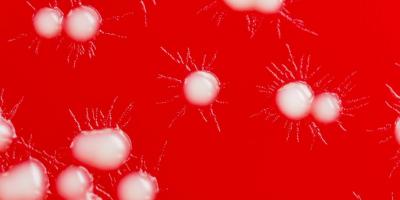

Аккаунт DayZ в Steam
Общая информация
DayZ - это популярная компьютерная игра в жанре выживания в открытом мире. Аккаунт в Steam позволяет игрокам сохранять свой прогресс, получать доступ к дополнительным функциям и участвовать в сообществе.
Создание аккаунта
Чтобы создать аккаунт DayZ в Steam, вам необходимо перейти на официальный сайт Steam и следовать инструкциям. Вам потребуется указать электронную почту, пароль и принять условия использования сервиса.
Вход в аккаунт
Для входа в свой аккаунт DayZ в Steam вам нужно открыть клиент Steam, ввести логин и пароль, которые вы указали при создании аккаунта.
Управление аккаунтом
В аккаунте DayZ в Steam вы можете управлять своими играми, настройками безопасности, а также просматривать свою историю покупок и общения с другими игроками.
 Цифровые игры
Цифровые игры